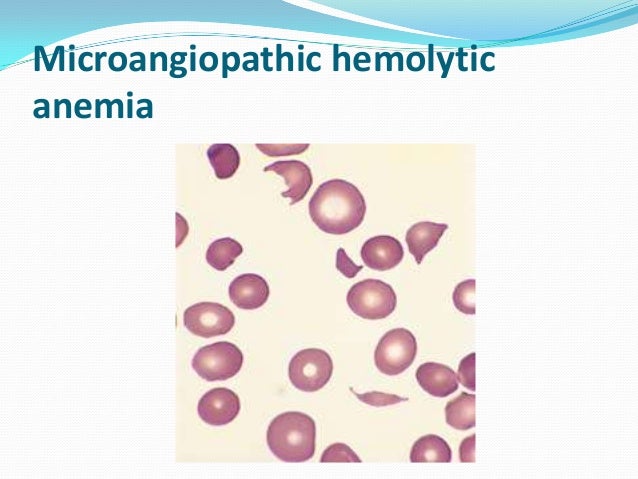

Treatment of a delayed hemolytic reaction is not needed unless there is evidence of brisk hemolysis. In the case of brisk hemolysis, treatment consists of fluids, antigen-negative (type O) blood transfusions, or red cell exchange.
Why can a transfusion reaction be fatal?
What is the cause for most fatal transfusion reactions? misidentification Hemolytic Transfusion Reaction associated with the infusion of incompatible RBC's Non Hemolytic Transfusion Reactions involves all other types of reactions that don't involve the hemolysis of rbc's Acute Hemolytic Reaction
What is a delayed adverse reaction?
Delayed adverse reactions (DARs) resulting from the parenteral administration of iodinated contrast agents are more common than previously appreciated. The definition of DARs has varied somewhat but usually means adverse events that begin 1 hour or longer after the administration of the contrast agent.
What are the signs and symptoms of hemolytic anemia?
You might get one of these:
- Reticulocyte count. This measures the number of young red blood cells in your body. ...
- Coombs' test. The doctor will do this test to see if your body is making antibodies against red blood cells.
- Peripheral smear. ...
- Bilirubin test. ...
- Haptoglobin test. ...
- Cold agglutinin titer. ...
What is delayed reaction?
DELAYED REACTION. An experimental technique for determining whether an animal or young child can remember the solution to a problem after a lapse of time. The method is used in studying thinking processes and learning ability .Adult human beings can learn any number of tasks that involve delays of short or even long duration.
How do you treat a hemolytic reaction?
Acute hemolytic reactions (antibody mediated) are managed as follows:Immediately discontinue the transfusion while maintaining venous access for emergency management.Anticipate hypotension, renal failure, and DIC.More items...•
How long can a delayed hemolytic reaction occur?
Acute hemolytic reactions happen within 24 hours of transfusion and delayed hemolytic reactions happen after 24 hours. Delayed reactions usually occur two weeks after but can go up to 30 days post transfusion.
What is the treatment of hemolytic reaction in the process of blood transfusion?
If the recipient's immune system attacks the red blood cells of the donor, it is called a hemolytic reaction. You can have an allergic reaction to a blood transfusion as well. These symptoms can include hives and itching. This reaction type is often treated with antihistamines.
What is delayed hemolytic transfusion reaction?
Delayed hemolytic transfusion reaction (DHTR) is a delayed reaction, that occurs days to weeks following a transfusion, characterized by mild anemia and/or hyperbilirubinemia and is one of the serious complications of blood transfusion.
What should you do if a patient has a delayed reaction to a blood transfusion?
What to do. Most delayed haemolytic reactions have a benign course and require no treatment, however life-threatening haemolysis with severe anaemia and renal failure may occur. If an antibody is identified, you may request antigen-negative blood if further transfusion is needed.
How can delayed hemolytic transfusion reaction be prevented?
Potential strategies to reduce the risk of delayed hemolytic transfusion reactions include a thorough transfusion history, and the transfusion of antigen-negative blood regardless of current antibody detection.
What medication is given for blood transfusion reaction?
Febrile non-hemolytic and allergic reactions are the most common transfusion reactions, but usually do not cause significant morbidity. In an attempt to prevent these reactions, US physicians prescribe acetaminophen or diphenhydramine premedication before more than 50% of blood component transfusions.
Which antibody is most commonly associated with delayed hemolytic transfusion reactions?
Unlike immediate reactions, antibodies most commonly involved in delayed hemolytic reactions are those in the Rh and Kidd systems rather than the ABO system.
Why do we give hydrocortisone before blood transfusion?
Due to their pharmacological actions mentioned above, acetaminophen, diphenhydramine and hydrocortisone are used for the prevention of allergic and febrile transfusion reactions, the pathophysiology of which is explained by Geiger 2007.
Which immunoglobulin is involved in the delayed hemolytic reaction?
IgG antibodies that efficiently activate complement (eg, those in the Kidd blood group system) tend to cause more intense extravascular hemolysis compared to antibodies that do not efficiently activate complement (eg, Rh and Kell system antibodies).
What is Taco in medicine?
Transfusion-associated circulatory overload (TACO) is a common transfusion reaction in which pulmonary edema develops primarily due to volume excess or circulatory overload.
Can you have a delayed reaction to a blood transfusion?
A delayed haemolytic reaction occurs when a patient develops an antibody directed against an antigen on transfused red cells. The antibody may cause shortened red cell survival, with clinical features of fever, jaundice and lower than expected haemoglobin following transfusion.
What is delayed hemolytic transfusion?
Delayed hemolytic transfusion reactions (DHTR) are caused by an anamnestic antibody response in the recipient precipitated by re-exposure to a non-ABO red cell antigen previously introduced by transfusion, transplantation or pregnancy .
How long does it take for a delayed hemolytic transfusion to occur?
Delayed hemolytic transfusion reactions (DHTRs) occur 3–10 days after the transfusion of RBC products that appear to be serologically compatible. These reactions occur in patients who have been alloimmunized to minor RBC antigens during previous transfusions and/or pregnancies; pretransfusion testing fails to detect these alloantibodies due to their low titer. After reexposure to antigen-positive RBCs, an anamnestic response occurs, with a rapid rise in antibody titer. Decreased survival of the transfused RBCs may result, primarily due to extravascular hemolysis. In the majority of cases, however, anamnestic antibody production does not cause detectable hemolysis. The term delayed serologic transfusion reaction (DSTR) defines reactions in which an anamnestic antibody is identified serologically, in the absence of clinical evidence of accelerated RBC destruction. Antigens implicated most often in DHTRs and DSTRs are in the Kidd, Duffy, Kell, and MNS systems, in order of decreasing frequency.
How long does it take for a DHTR to show up?
DHTR is usually suspected 3 to 10 days after transfusion, when clinical symptoms associated with hemolysis are observed and/or serologic findings consistent with DHTR are noted ( Table 49-4 ).
Why do DHTRs occur?
DHTRs generally occur in patients who have been alloimmunized to RBC antigens by previous transfusions or pregnancies. 2. Because the titer has decreased below detectable levels, the implicated antibody is not detected in pretransfusion antibody screening or compatibility testing. 3.
Why is post-transfusion testing so difficult?
One final note regarding the serologic evaluation of a transfusion reaction: posttransfusion testing may be complicated and difficult to interpret because of the possibility of autoantibodies or the involvement of medications. In such circumstances, referral to the pretransfusion specimen is often helpful. In cases of more complex evaluations, consultation with an expert serologist is recommended to detect and identify new alloantibodies in the patient's plasma, which may be responsible for a hemolytic transfusion reaction.
What causes DHTRs?
The cause of DHTRs is the delayed generation of an antibody to a donor antigen to which the recipient has been previously exposed. The culprit antibody binds a non-ABO group such as the Rh, Kidd, Kell, or Duffy groups. The diagnosis of a DHTR may be difficult.
What antigens should be matched for sickle cell?
Patients with sickle cell disease or thalassemia should receive blood matched at a minimum for Rh (D, C, c, E, and e) and K antigens. The more antigen matched the units are the less likelihood of delayed hemolytic or serologic transfusion reactions.
How to treat hemolytic transfusion reactions?
Treatment for hemolytic transfusion reactions is mainly supportive care. Reactions can range from mild to severe. As mentioned before, the first step is always to stop the transfusion. If unsure of the diagnosis, then one should send the blood for testing as discussed previously. However, if clinical suspicion is high or symptoms are severe, e.g., hypotension, immediate resuscitation should be started. Ensure the patient has good intravenous access. Aggressive hydration is usually recommended with normal saline to maintain a urine output at least 1 ml/kg/hr. This is to reduce the likelihood of complications of free hemoglobin in the blood stream such as acute kidney injury or disseminated intravascular coagulation. Sometimes diuretics are used to achieve adequate urinary output. If the patient does have disseminated intravascular coagulation (DIC), it will also need to be managed with appropriate blood products. [8][9][10]
How long does it take for a hemolytic reaction to occur?
Immune hemolytic transfusion reactions are divided into acute versus delayed hemolytic reactions. Acute hemolytic reactions happen within 24 hours of transfusion and delayed hemolytic reactions happen after 24 hours. Delayed reactions usually occur two weeks after but can go up to 30 days post transfusion.
What is hemolysis in blood?
Hemolysis is described as rupture of red blood cells and leakage of their contents. The site of hemolysis can be intravascular (in circulation) or extravascular (in reticuloendothelial system). Hemolytic transfusion reactions can be immune or non-immune mediated. [1][2][3]
What is the term for the rupture of red blood cells?
Hemolysis is the rupture of red blood cells, and can occur intravascularly, or in the circulation, or extravascularly, or in the reticuloendothelial system. Hemolytic transfusion reactions can be immune or non-immune mediated. Immune hemolytic transfusions reactions occur due to mismatch or incompatibility of the patient with the donor products.
What is hemolysis in transfusion?
Hemolytic transfusion reactions are one of the possible complications from transfusions. Hemolysis is described as rupture of red blood cells and leakage of their contents. The site of hemolysis can be intravascular (in circulation) or extravascular (in reticuloendothelial system).
Why is my transfusion delayed?
Delayed transfusion reactions usually are caused by an amnestic response of the immune system to a foreign red blood cell antigen from previous exposure , for example, pregnancy or previous transfusions. Hemolysis is mostly extravascular and less clinically dramatic compared to the acute hemolytic reaction.
How many transfusions are delayed hemolytic?
Delayed hemolytic transfusion reaction incidence is unknown because most patients are asymptomatic, so it is under reported. There is a large range from studies with estimates ranging from approximately 1:800 transfusion s to 1:11,000 transfusions. The incidence of non-immune hemolytic reactions is also not known; however, it is thought to be very rare. Many systems have been put in place to try to reduce the incidence of hemolytic transfusion reactions due to human and machine error.
What is delayed hemolytic transfusion reaction?
Delayed hemolytic transfusion reaction (DHTR) is an unpredictable and severe complication of transfusion, especially in Sickle Cell Disease (SCD) patients ( Habibi Am J Hematol 2016 ). The clinical presentation is a vaso occlusive crisis (VOC), often associated with one or more organ failures, after packed red blood cell transfusion (pRBC). The hypothesis of complement activation through the classical pathway by alloantibodies and/or the alternative pathway by free heme (released by hemolysis) suggests that an inhibitor of complement activation may be a treatment option for DHTR.
How long after pRBC transfusion does DHTR show?
DHTR diagnosis associated VOC signs occurring 5 to 20 days after pRBC transfusion, with no other cause for intravascular hemolysis, and one or more of the following:
Is anti-C5 good for DHTR?
In association with other therapies (EPO, plasma exchange, limiting pRBC transfusions), anti-C5 can be a treatment option for severe DHTR despite its high cost, in the absence of effective alternatives.
How to reduce the burden of DHTR?
Prevention is the key to reducing the overall burden of DHTR in the SCD population; extended RBC phenotyping and antigen matching of transfused units have significantly reduced alloimmunization rates. There is growing evidence for genetic testing of patients with SCD, particularly for RHD and RHCE loci, which warrants further evaluation from both clinical and cost-effectiveness standpoints. The future may see molecular testing of both patients and donors, as high throughput sequencing becomes less costly. This would enable an even more individualized approach to transfusion medicine.
What are the risk factors for RBC alloimmunization?
First, children have been reported to have significantly lower alloimmunization compared to older patients even after accounting for total number of RBC units transfused (Rosse et al, 1990 ). Second, females are also at increased risk, owing in part to increased RBC antigen exposure in pregnancy (Reisner et al, 1987; Schonewille et al, 2006 ). Third, genotype may be a risk factor; DHTR in SCD occurs most frequently but not exclusively in patients with sickle cell anaemia (HbSS and HbS/β 0 thalassaemia), compared to HbSC patients, although this may reflect the greater use of transfusion in the former genotypic group of patients. However, as illustrated by Case 4, DHTR is not restricted to sickle cell anaemia. Fourth, the risk of alloimmunization increases with increasing number of transfusions (Rosse et al, 1990; Vichinsky et al, 1990; Bauer et al, 2007) but most alloimmunization occurs after fewer than 15 transfusions (Rosse et al, 1990 ). This may explain why the alloimmunization rate in patients on chronic exchange-transfusion is not greater than that in patients on chronic simple transfusion (Wahl et al, 2012; Fasano et al, 2015 ). Fifth, the clinical context of the RBC transfusion in SCD may play a role in the development of alloimmunization and DHTR; specifically, the risk of alloimmunization in SCD is increased if the transfusion is delivered in an acute setting when the patient is in an inflammatory state (Yazer et al, 2009; Fasano et al, 2015; Vidler et al, 2015 ).
What causes DHTR?
The key cause of DHTR is a recipient's production of alloantibodies against the donor's RBC antigens after transfusion. These alloantibodies may be either new antibodies, or evanescent antibodies that were undetectable prior to transfusion, but where re‐exposure to a RBC antigen triggered an anamnestic antibody response and activation of complement (Stowell et al, 2012 ). Antibody evanescence, a phenomenon crucial to the pathogenesis of DHTR in general, has been reported for 37–51% of antibodies detected in the series reported by Rosse et al ( 1990) and Harm et al ( 2014 ). The latter group reported that in 63.6% of alloimmunized patients, one or more alloantibodies evanesced; evanescing antibodies were found in all blood group systems.
Why are SCD patients more likely to be alloimmunized?
It has been suggested that one possible reason for the relatively high incidence of alloimmunization observed in the SCD population is the mismatch in the RBC antigens expressed in patients of African descent and donors of primarily Northern European descent. Alloimmunization rates are lower in patients who are transfused RBC units from ethnically similar donors [e.g., in Ugandan (Natukunda et al, 2010) and Jamaican (Olujohungbe et al, 2001) populations] but the lower alloimmunization rate in SCD populations in these countries may also be related to an overall lower exposure to RBC transfusion. In the US, using a strategy of purposefully sourcing black donors has reduced HTR rates (Sosler et al, 1993; Wayne et al, 1993 ). More recently, Chou et al ( 2013) found that a significant proportion of SCD patients receiving phenotypic Rh- matched RBC transfusion from exclusively African-American donors still became alloimmunized. Molecular analyses of the RH genes in SCD patients and African-American donors revealed remarkable RH allelic diversity in this population and mismatch between serological Rh phenotype and RHD or RHCE genotype due to variant RH alleles in 87% of individuals (Chou et al, 2013 ). This suggests that for some SCD patients, RH genotyping in addition to serological typing is required to identify compatible RBC.
How to prevent alloimmunization in SCD?
Strategies to prevent alloimmunization in SCD include ( i) transfusion from ethnically-matched donors and (ii) extended RBC antigen matching. Notably, using ethnically-matched blood may reduce rather than eliminate DHTR given the significant RBC antigen heterogeneity in the black population (Chou et al, 2013 ). This is complicated by the high incidence of sickle cell trait in black donors; blood from donors with sickle cell trait causes blockages of the filters during leucodepletion (Beard et al, 2004 ); in addition, the use of AS donors complicates tracking of HbS versus HbA levels.
Is blood transfusion effective?
Blood transfusion is the most effective treatment for the prevention and management of many acute and chronic complications of sickle cell disease (SCD), including primary and secondary stroke prevention, acute management of stroke, acute chest syndrome (ACS), splenic sequestration and acute multi-organ failure (Adams et al, 1998; DeBaun et al, 2014; National Institutes of Health: National Heart Lung and Blood Institute 2014 ). The beneficial effects of transfusion therapy observed in recent clinical trials are expanding their indication and utilization, contributing to an increased use of blood (Drasar et al, 2011; Steinberg, 2014 ). Nonetheless, transfusion is not without risks; haemolytic transfusion reactions and iron overload are common side effects, while transmission of infections remains a significant issue in some countries. Alloimmunization to red blood cell (RBC) antigens is a major complication of transfusion and the underlying cause of the majority of delayed haemolytic transfusions reactions (DHTR). DHTR occurs from 24 h up to 21 d after a transfusion. It is a secondary immune phenomenon, typically arising after recrudescence of an alloantibody to which the patient had been immunized, but which later evanesced and became undetectable by the standard compatibility tests. However, particularly in the setting of SCD, new alloantibodies are not always detected in the plasma or eluate of the patients with an otherwise typical DHTR, invoking other pathological mechanisms. A key challenge is that DHTR in SCD is under-recognized, not only because it mimics the clinical events in acute vaso-occlusive crisis (VOC), but because serological markers of alloimmunization are often equivocal. Furthermore, DHTR itself often triggers VOC in SCD, which can lead to life-threatening complications. The first DHTR cases in SCD were probably documented by Diamond et al ( 1980 ), who described four patients with DHTRs presenting as sickle cell crises. Diamond emphasized then, that DHTR should be considered whenever a recently transfused patient with SCD presents with VOC-type symptoms.
Is a patient at risk for Hb-induced tubulopathy?
Patients are at risk of developing a Hb‐induced tubulopathy and associated acute kidney injury, hence maintaining fluid balance, renal function and a good urine output, is of prime importance. Clinicians must be vigilant for the development of other acute sickle phenomena such as ACS, stroke and multi‐organ failure.
What are the strategies to reduce the risk of delayed hemolytic transfusion reactions?
Potential strategies to reduce the risk of delayed hemolytic transfusion reactions include a thorough transfusion history, and the transfusion of antigen-negative blood regardless of current antibody detection . Regional or national RBC alloantibody registries such as those in place in Kansas City, Quebec, and the Netherlands are invaluable. Routine post-transfusion or postpartum antibody screens have been proposed but are unlikely to be adopted because of cost.
How long does it take for a delayed hemolytic transfusion to occur?
Typical presentation of a delayed hemolytic transfusion reaction occurs 5-21 days after the offending transfusion. The patient presents with unexplained anemia, low grade fever, jaundice, or worsening renal function. Temporal association with transfusion is not always appreciated. The appropriate lab tests for investigation include bilirubin, LDH, reticulocyte count, and direct antiglobulin test (DAT).
How many RBC antibodies are undetectable?
According to a Dutch study in 2000, 25% of all RBC antibodies become undetectable over time. Antibodies detected with a more sensitive technique (such as LISS instead of albumin) may be less persistent. Kidd antibodies are notoriously evanescent, and a culprit in many delayed hemolytic reactions for this reason. In another study of U.S. military veteran men, the prevalence of RBC alloantibodies was 2.2%. Among a subset of these alloimmunized men who underwent serial blood bank testing (a median of 6 times over 16 months), 20% of pre-existing antibodies disappeared, and half of newly-identified antibodies disappeared.
What is the management of sphenocytes?
Management consists of serial monitoring of blood counts, adequate hydration, and transfusion of antigen-negative blood for all subsequent transfusions.
Is anti-S transfused blood negative?
An eluate confirmed the presence of anti-S on transfused donor cells. The patient’s pre-transfusion specimen typed as S negative. Transfusion recommendation was updated to crossmatch blood negative for E, c, K, and S. He had hyperbilirubinemia that was improving by this time, consistent with a delayed hemolytic transfusion reaction, although the event was not reported as a reaction by the clinical team.
What is delayed hemolytic transfusion?
A delayed hemolytic transfusion reaction is a potentially significant adverse event caused by antibody mediated removal of recently transfused red cells due to an amnestic immune response from antibodies against an incompatible minor red blood cell antigen
How long does it take for hemoglobin to drop after a transfusion?
Essential features. This transfusion reaction can cause an unexpected drop in hemoglobin 3 - 28 days after a transfusion and can cause clinically observed symptoms, including fever. Caused by an amnestic immune response, where red cell alloantibodies increase in titer and trigger removal of incompatible red cells via splenic macrophages.
What is the severity of a reaction?
Reaction severity depends on the thermal range (a wider thermal range can be more severe than a narrow thermal range), antibody specificity (antibodies to some antigens, such as anti-Jk or anti-K, tend to more commonly result in hemolysis than others), and IgG subclass (the subclasses that bind well to complement and Fc receptors on phagocytic cells, such as IgG3 and IgG1, can result in more severe reactions)
What antigens should be used for red blood cell transfusion?
Patients receiving chronic therapeutic red cell transfusions should have a red blood cell phenotype completed (molecular methods are now preferred) for at least Rh, Kell, Duffy, Kidd and MNS antigens before initiation of transfusion therapy.
When did DHTR fall?
In one single institution study, DHTR incidence has fallen between 1999 and 2007, and was associated with a transition from polyethylene glycol (PEG) to gel technology
Can you use antipyretics for fever?
Specific intervention usually not indicated but symptomatic or supportive management can safely be used (i. e. antipyretics for fever)
Is red cell transfusion negative for K-antigen?
All future red cell transfusions should be negative for the K-antigen. Please be aware that increased time may be needed to procure antigen matched blood and such red cell units may not be available quickly in an emergency. Symptoms associated with a delayed reaction, such as fever, will be self limited, and can be managed symptomatically. Please contact the medical director on service if you have additional questions about this case.
